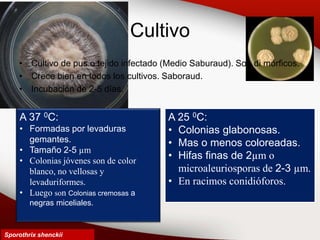
Cultivo
• Cultivo de pus o tejido infectado (Medio Saburaud). Son di mórficos.
• Crece bien en todos los cultivos. Saboraud.
• Incubación de 2-5 días.
A 37 0C:
• Formadas por levaduras
gemantes.
• Tamaño 2-5 µm
• Colonias jóvenes son de color
blanco, no vellosas y
levaduriformes.
• Luego son Colonias cremosas a
negras miceliales.
A 25 0C:
• Colonias glabonosas.
• Mas o menos coloreadas.
• Hifas finas de 2µm o
microaleuriosporas de 2-3 µm.
• En racimos conidióforos.
Sporothrix shenckii

Este documento describe cuatro hongos patógenos: Sporothrix schenckii, Fonsecae pedrosoi, Scedosporium apiospermum y Madurella spp. Describe las características morfológicas, el hábitat, la patogenicidad y las formas clínicas de las infecciones causadas por S. schenckii y F. pedrosoi.